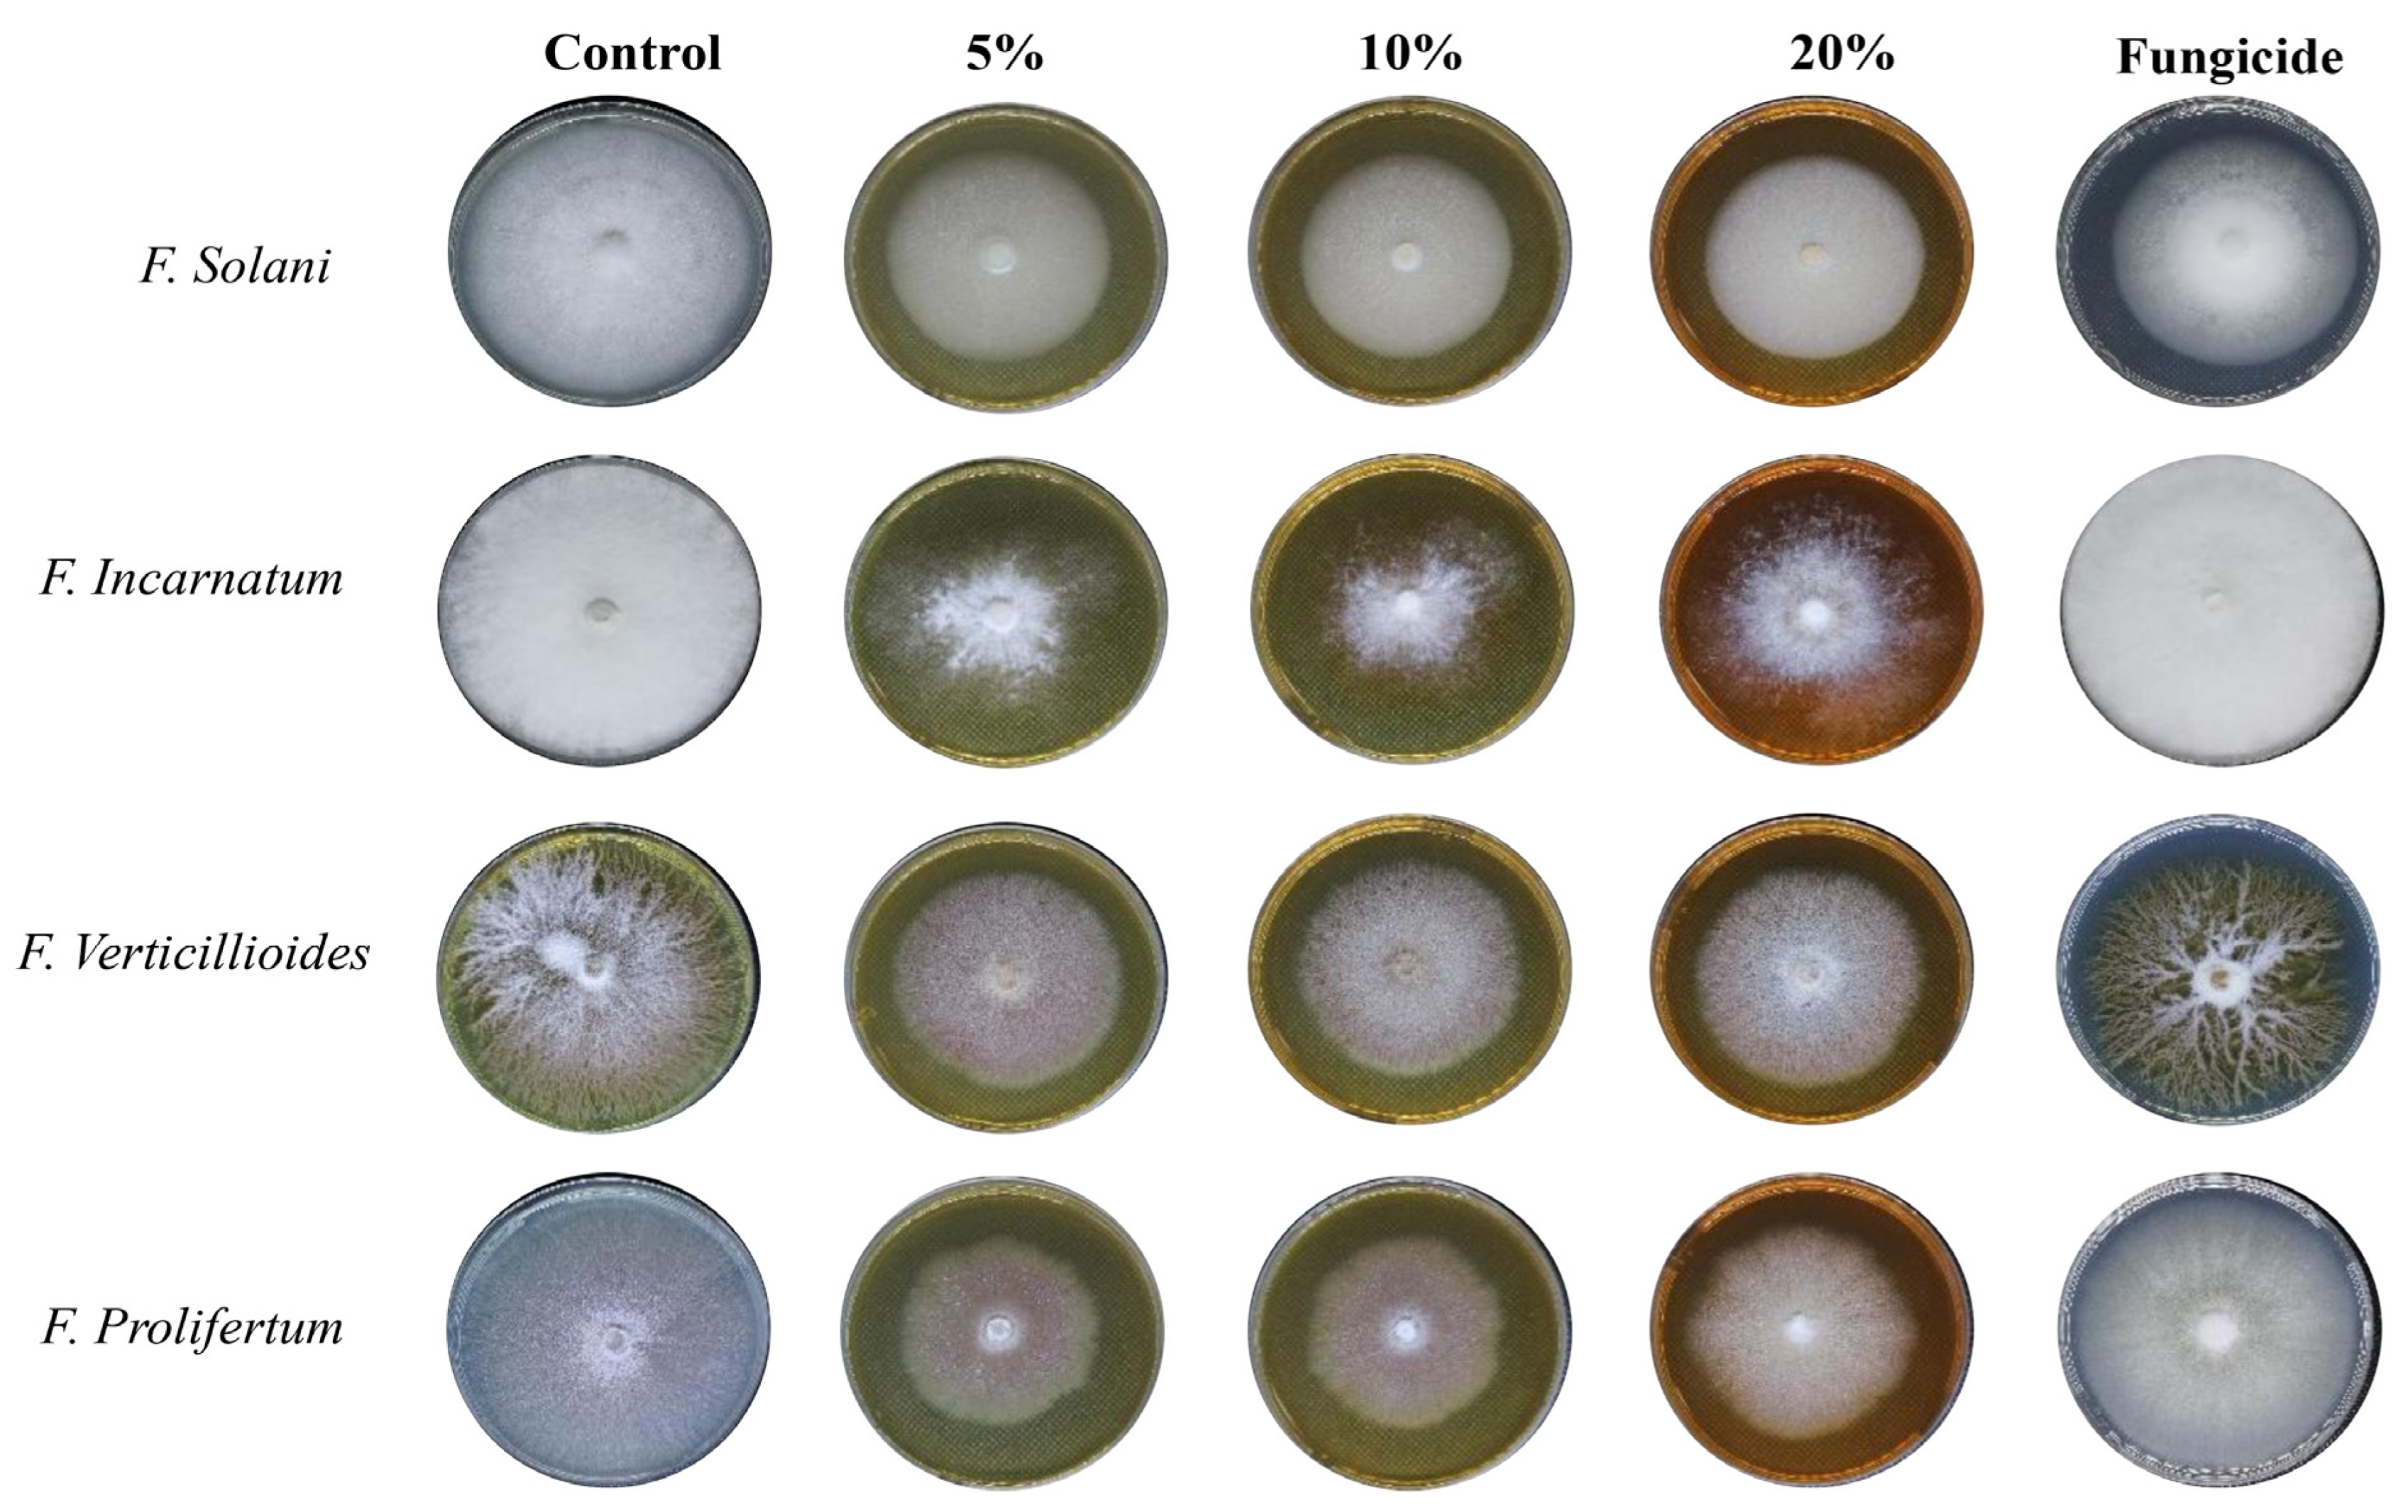
Nanomaterials 14 00088 g005
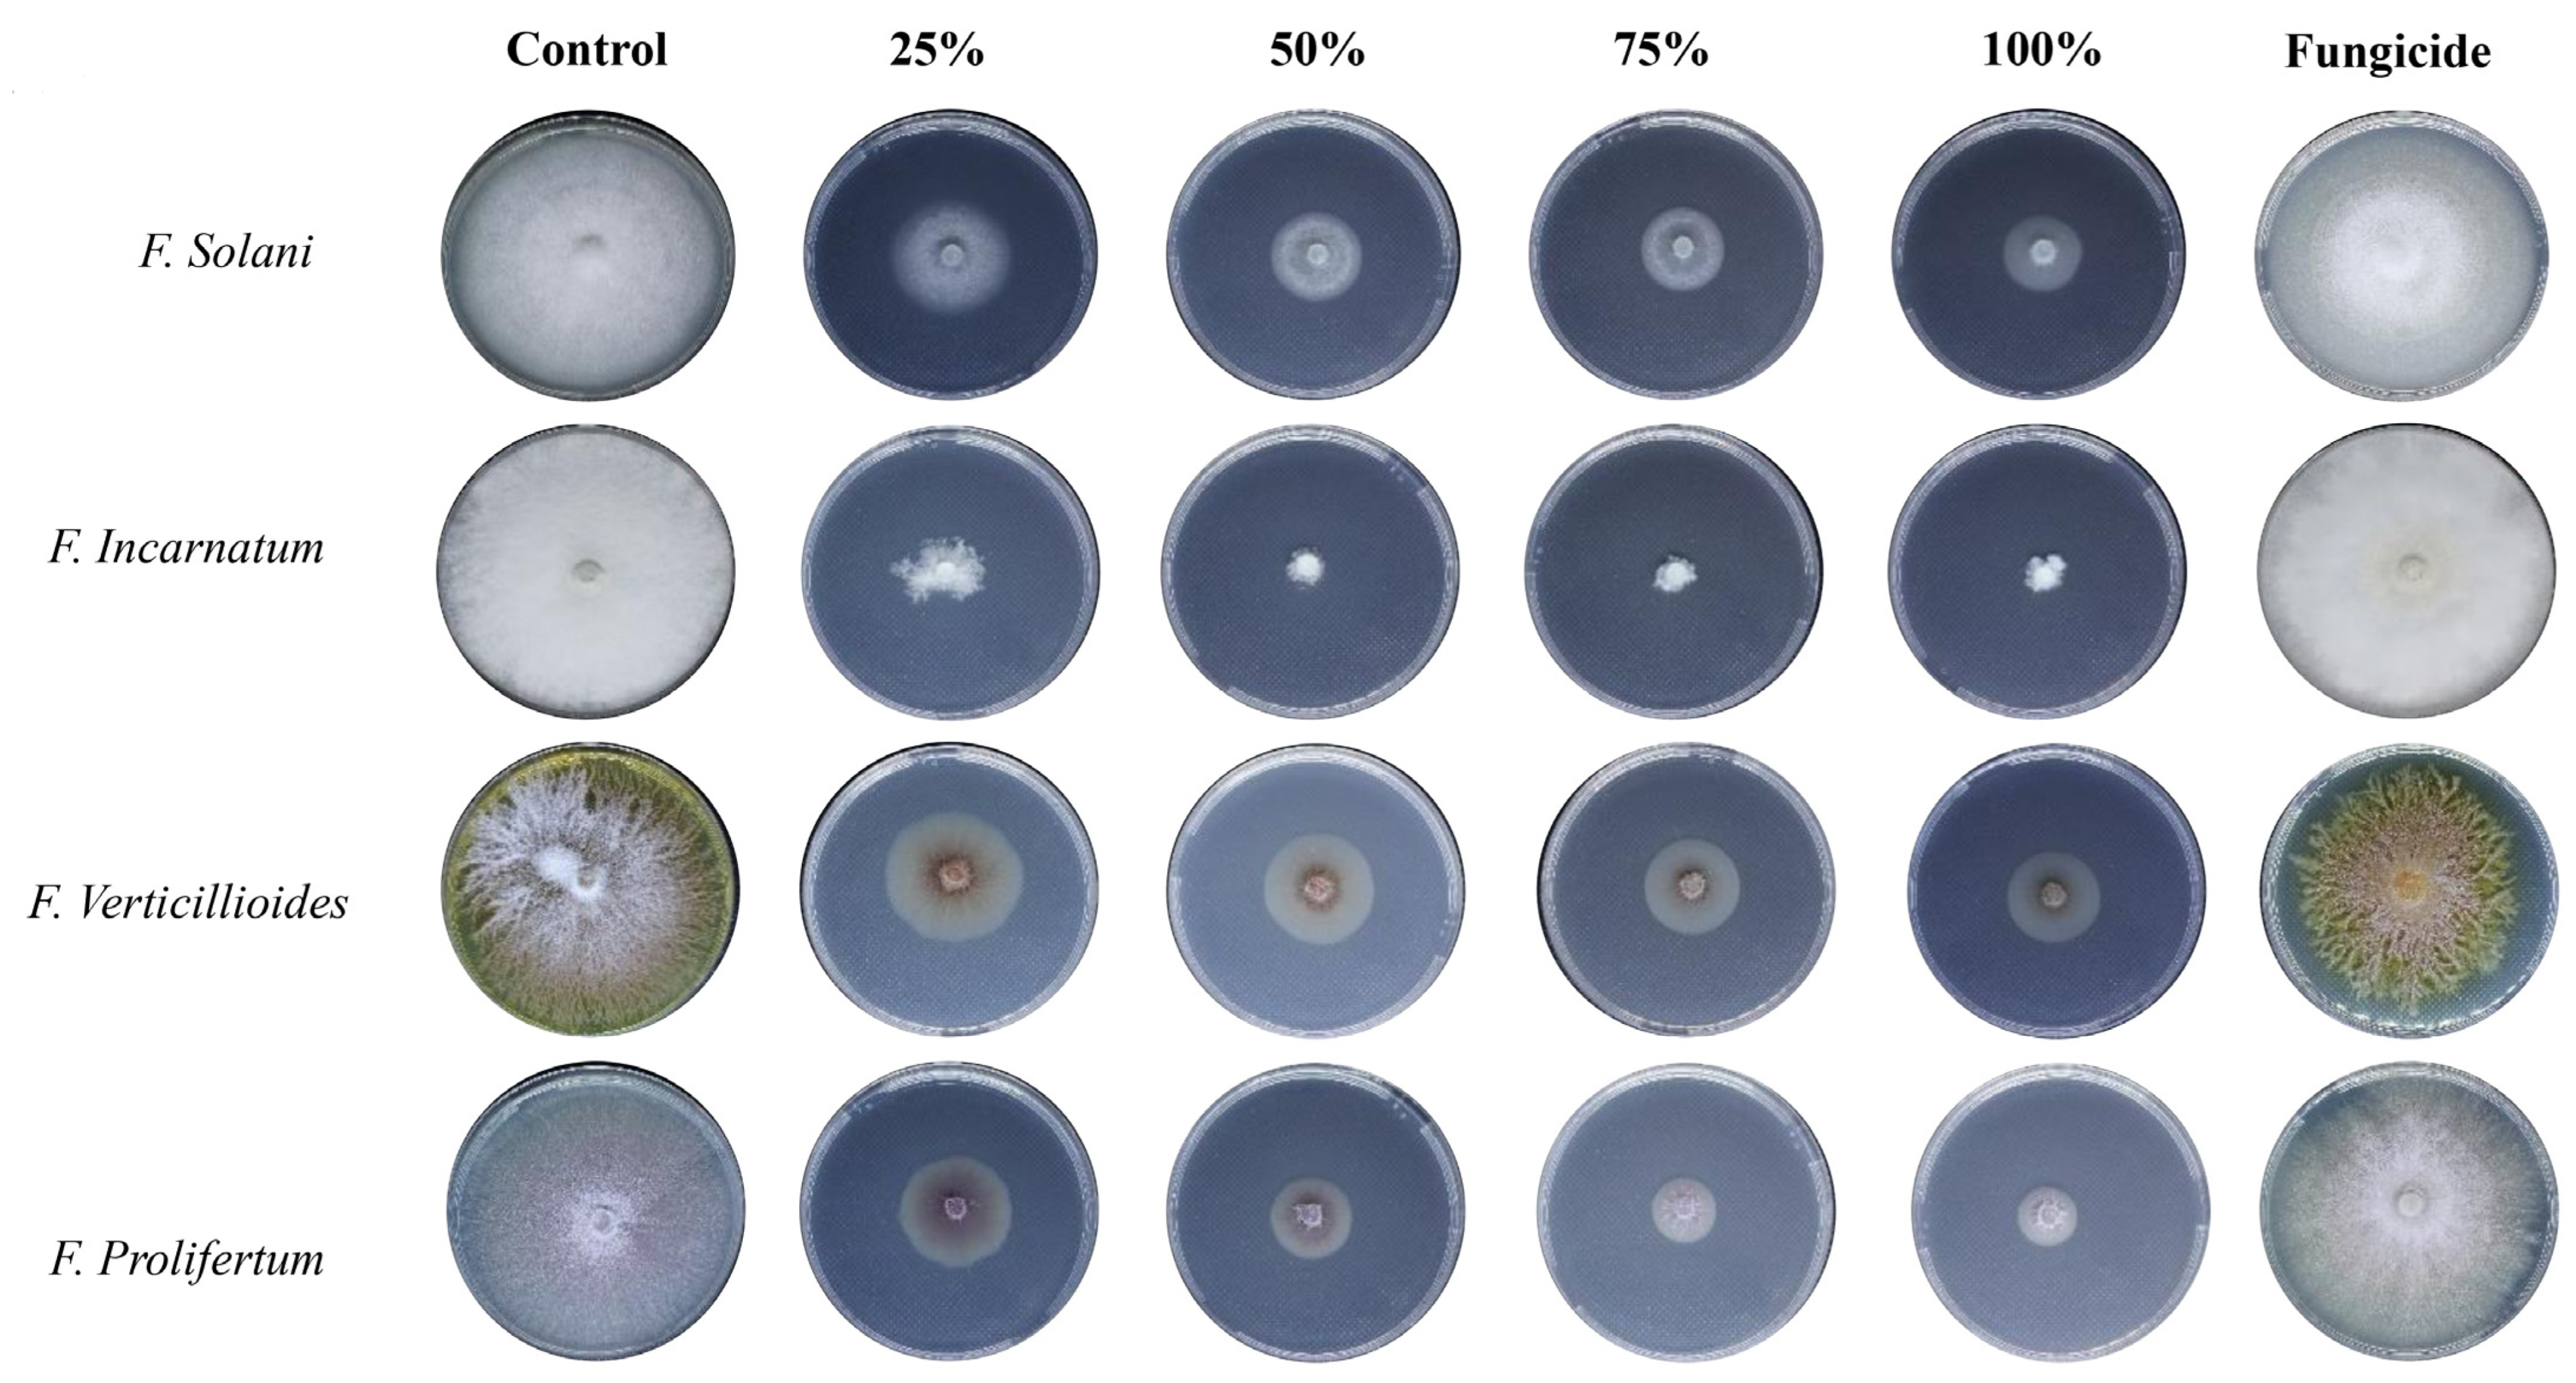
Nanomaterials 14 00088 g007
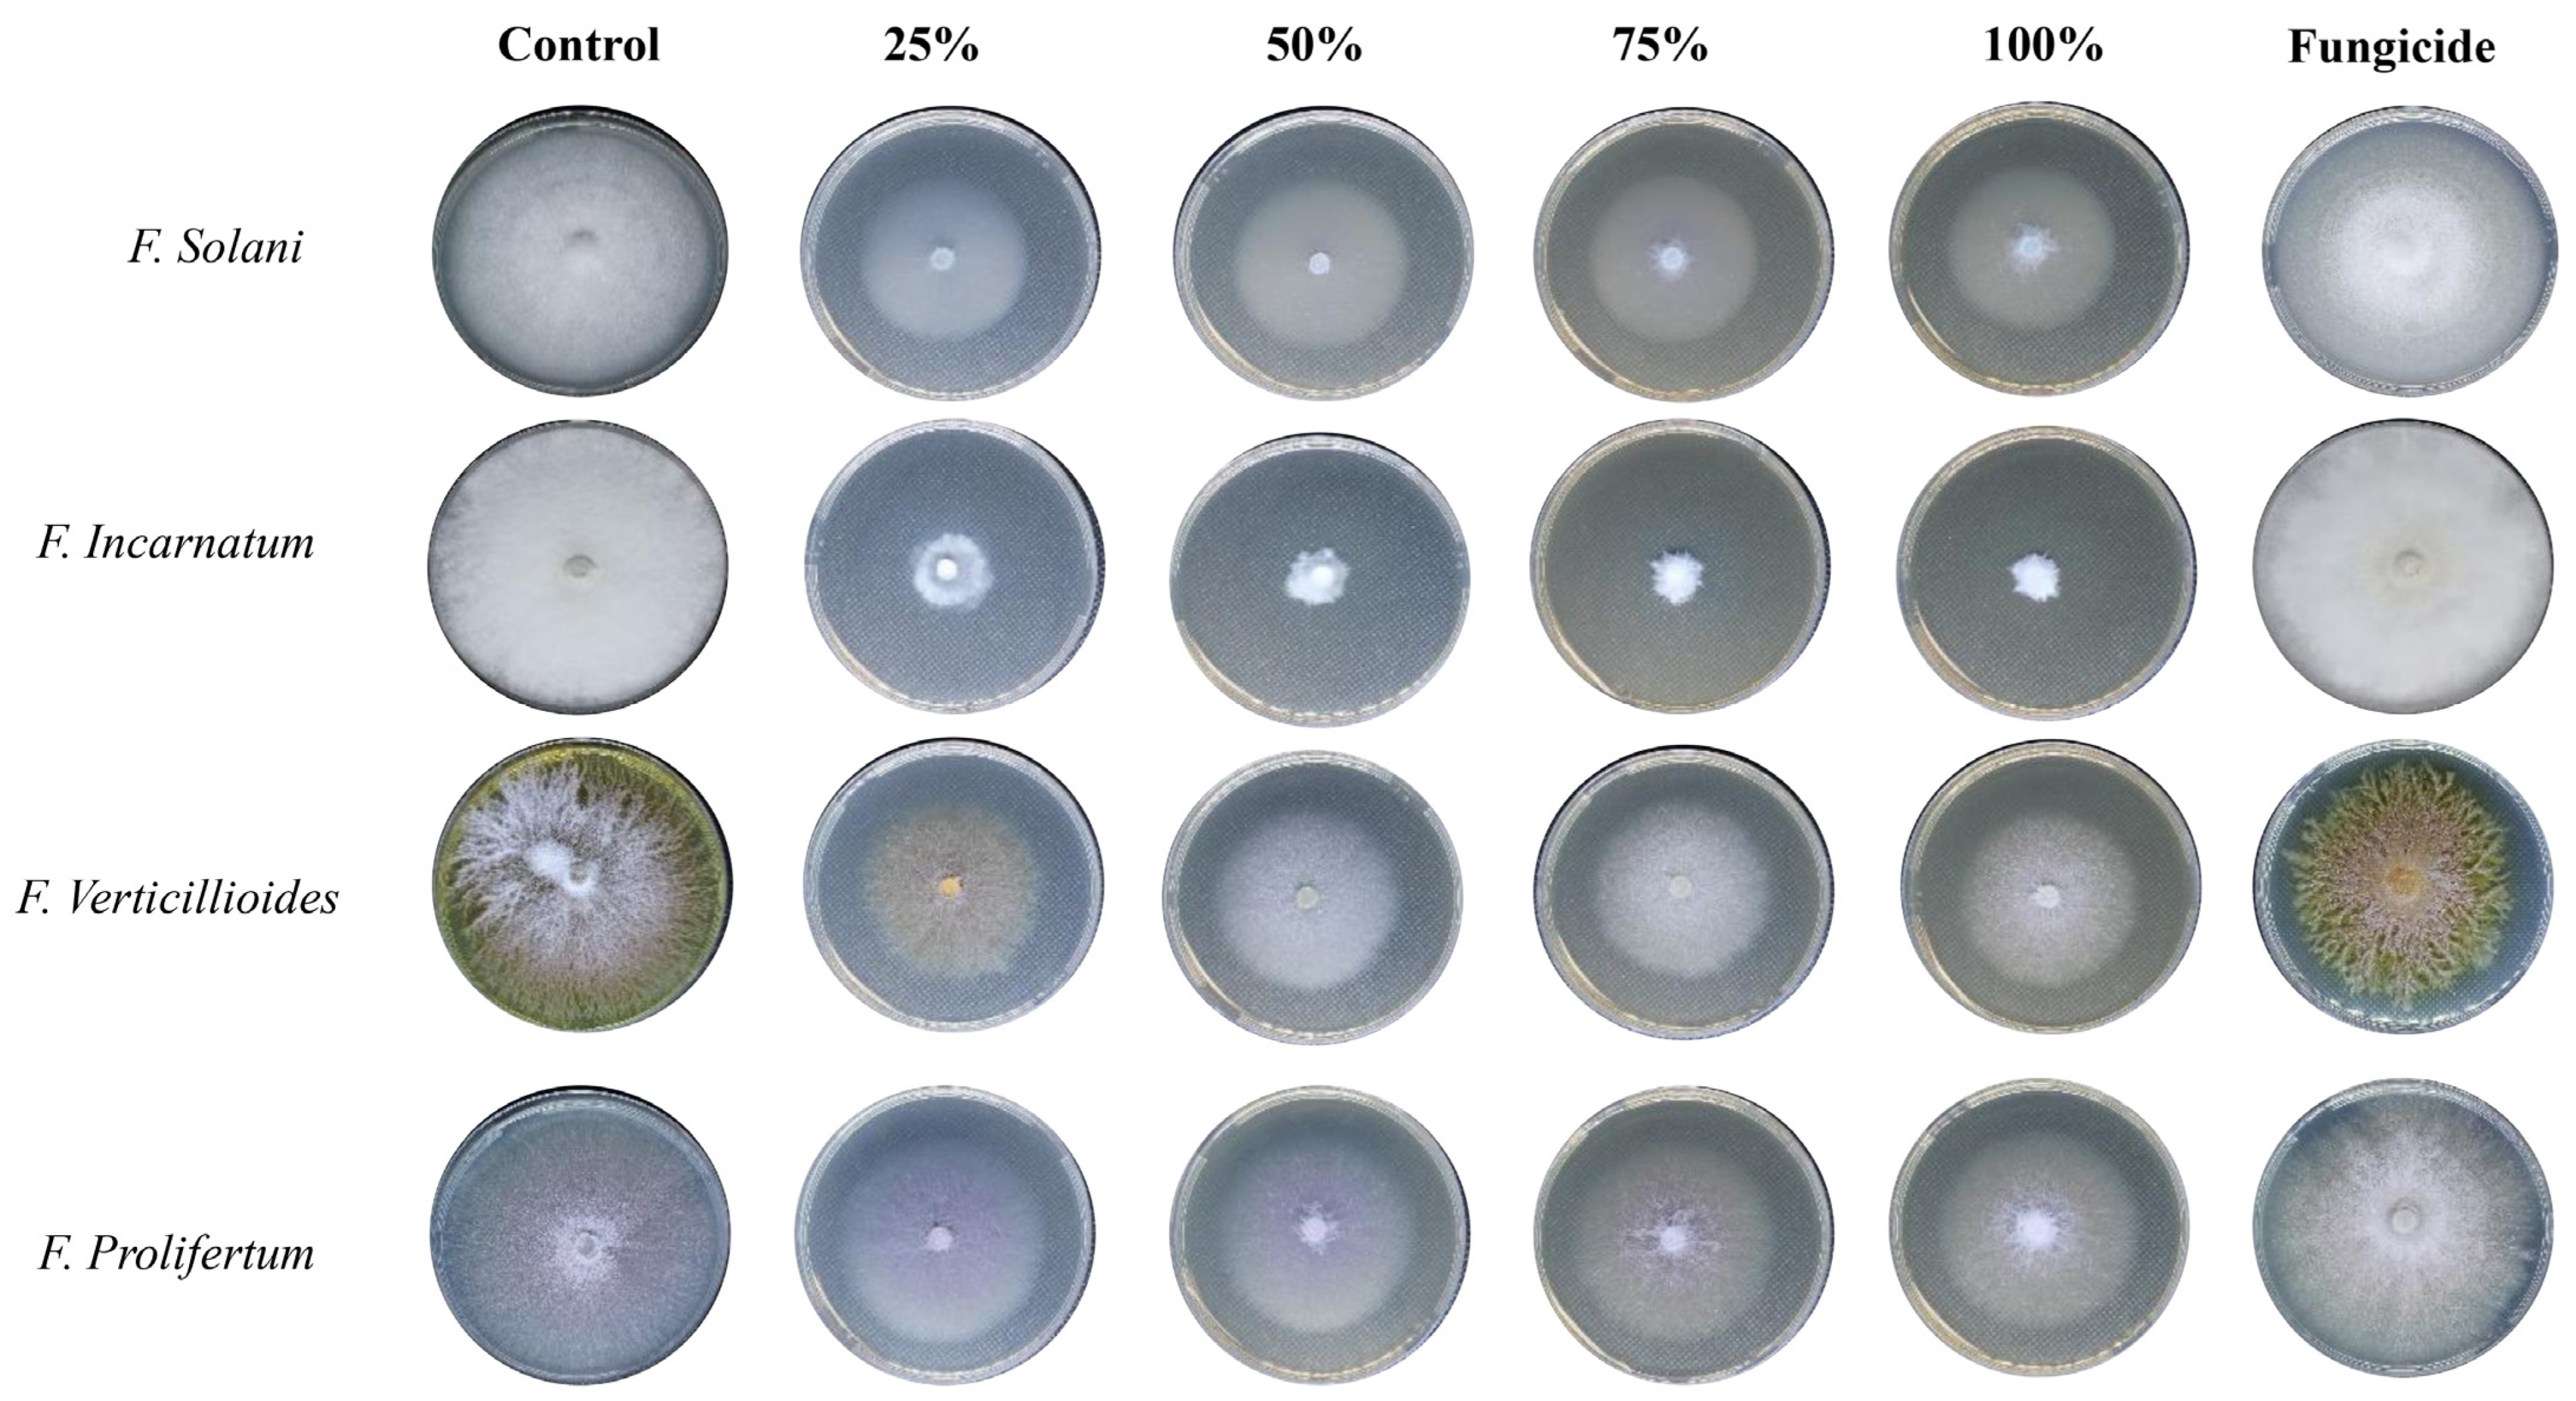
Nanomaterials 14 00088 g008

The Antifungal Activities of Silver Nano-Aggregates Biosynthesized from the Aqueous Extract and the Alkaline Aqueous Fraction of Rhazya stricta against Some Fusarium Species
Abstract
:1. Introduction
2. Materials and Methods
2.1. Preparation of Plant Extracts
2.2. Preparation of AgNPs
2.3. Characterization of Biogenic AgNPs
2.4. Fusarium Species
2.5. Evaluation of the Fungistatic Activity
2.6. Scanning of the Fungal Growth Inhibition and Produced Germs by Light Microscopy
2.7. Statistical Analysis
3. Results
4. Discussion
5. Conclusions
Supplementary Materials
Funding
Data Availability Statement
Acknowledgments
Conflicts of Interest
References
- Bukhari, N.A.; Al-Otaibi, R.A.; Ibhrahim, M.M. Phytochemical and taxonomic evaluation of Rhazya stricta in Saudi Arabia. Saudi J. Biol. Sci. 2017, 24, 1513–1521. [Google Scholar] [CrossRef] [PubMed]
- Abdel-Rahman, A.; Almalki, M. Growth and metabolic responses of Rhazya stricta Decne to habitat diversity in Makkah region, Saudi Arabia. Egypt. J. Bot. 2018, 58, 157–170. [Google Scholar] [CrossRef]
- Akhgari, A.; Oksman-Caldentey, K.M.; Rischer, H. Biotechnology of the medicinal plant Rhazya stricta: A little investigated member of the Apocynaceae family. Biotechnol. Lett. 2017, 39, 829–840. [Google Scholar] [CrossRef] [PubMed]
- Bhadane, B.S.; Patil, M.P.; Maheshwari, V.L.; Patil, R.H. Ethnopharmacology, phytochemistry, and biotechnological advances of family Apocynaceae: A review. Phytother. Res. 2018, 32, 1181–1210. [Google Scholar] [CrossRef] [PubMed]
- Hajrah, N.H.; Abdul, W.M.; Abdul-Hameed, Z.H.; Alarif, W.M.; Al-Abbas, N.S.A.; Ayyad, S.N.; Omer, A.M.S.; Mutawakil, M.Z.; Hall, N.; Obaid, A.Y.; et al. Gene Expression Profiling to delineate the anticancer potential of a new alkaloid isopicrinine from Rhazya stricta. Integr. Cancer Ther. 2020, 19, 1534735420920711. [Google Scholar] [CrossRef] [PubMed]
- Albeshri, A.; Baeshen, N.A.; Bouback, T.A.; Aljaddawi, A.A. A Review of Rhazya stricta Decne Phytochemistry, bioactivities, pharmacological activities, toxicity, and folkloric medicinal uses. Plants 2021, 10, 2508. [Google Scholar] [CrossRef] [PubMed]
- Abdul-Hameed, Z.H.; Alarif, W.M.; Sobhi, T.R.; Abdel-Lateff, A.; Ayyad, S.N.; Badria, F.A.; Saber, J. New cytotoxic indole-type alkaloids obtained from Rhazya stricta leaves. S. Afr. J. Bot. 2021, 137, 298–302. [Google Scholar] [CrossRef]
- Baeshen, M.; Khan, R.; Bora, R.S.; Baeshen, N.A. Therapeutic potential of the folkloric medicinal plant Rhazya stricta. Biol. Syst. Open Access 2015, 5, 151. [Google Scholar] [CrossRef]
- Jain, A.; Sarsaiya, S.; Wu, Q.; Lu, Y.; Shi, J. A review of plant leaf fungal diseases and its environment speciation. Bioengineered 2019, 10, 409–424. [Google Scholar] [CrossRef]
- Shuping, D.S.S.; Eloff, J.N. The use of plants to protect plants and food against fungal pathogens: A review. Afr. J. Tradit. Complement. Altern. Med. 2017, 14, 120–127. [Google Scholar] [CrossRef]
- Arie, T. Fusarium diseases of cultivated plants, control, diagnosis, and molecular and genetic studies. J. Pestic. Sci. 2019, 44, 275–281. [Google Scholar] [CrossRef] [PubMed]
- Zhang, N.; O’Donnell, K.; Sutton, D.A.; Nalim, F.A.; Summerbell, R.C.; Padhye, A.A.; Geiser, D.M. Members of the Fusarium solani species complex that cause infections in both humans and plants are common in the environment. J. Clin. Microbiol. 2006, 44, 2186–2190. [Google Scholar] [CrossRef] [PubMed]
- Sun, S.; Lui, Q.; Han, L.; Ma, Q.; He, S.; Li, X.; Zhang, H.; Zhang, J.; Liu, X.; Wang, L. Identification and characterization of Fusarium proliferatum, a new species of fungi that cause fungal keratitis. Sci. Rep. 2018, 8, 4859. [Google Scholar] [CrossRef] [PubMed]
- Pathak, V.M.; Verma, V.K.; Rawat, B.S.; Kaur, B.; Babu, N.; Sharma, A.; Dewali, S.; Yadav, M.; Kumari, R.; Singh, S.; et al. Current status of pesticide effects on environment, human health and it’s eco-friendly management as bioremediation: A comprehensive review. Front. Microbiol. 2022, 13, 962619. [Google Scholar] [CrossRef] [PubMed]
- Bayda, S.; Adeel, M.; Tuccinardi, T.; Cordani, M.; Rizzolio, F. The History of nanoscience and nanotechnology: From chemical-physical applications to nanomedicine. Molecules 2019, 25, 112. [Google Scholar] [CrossRef] [PubMed]
- Khan, Y.; Sadia, H.; Ali Shah, S.Z.; Khan, M.N.; Shah, A.A.; Ullah, N.; Ullah, M.F.; Bibi, H.; Bafakeeh, O.T.; Khedher, N.B.; et al. Classification, synthetic, and characterization approaches to nanoparticles, and their applications in various fields of nanotechnology: A review. Catalysts 2022, 12, 1386. [Google Scholar] [CrossRef]
- Bruna, T.; Maldonado-Bravo, F.; Jara, P.; Caro, N. Silver nanoparticles and their antibacterial applications. Int. J. Mol. Sci. 2021, 22, 7202. [Google Scholar] [CrossRef]
- Silver, S. Bacterial silver resistance: Molecular biology and uses and misuses of silver compounds. FEMS Microbiol. Rev. 2003, 27, 341–353. [Google Scholar] [CrossRef]
- Elashnikov, R.; Lyutakov, O.; Kalachyova, Y.; Solovyev, A.; Svorcik, V. Tunable release of silver nanoparticles from temperature-responsive polymer blends. React. Funct. Polym. 2015, 93, 163–169. [Google Scholar] [CrossRef]
- Miranda, A.; Akpobolokemi, T.; Chung, E.; Ren, G.; Raimi-Abraham, B.T. pH alteration in plant-mediated green synthesis and its resultant impact on antimicrobial properties of silver nanoparticles (AgNPs). Antibiotics 2022, 11, 1592. [Google Scholar] [CrossRef]
- Komazec, B.; Cvjetko, P.; Balen, B.; Letofsky-Papst, I.; Lyons, D.M.; Peharec Štefanić, P. The Occurrence of Oxidative Stress Induced by Silver Nanoparticles in Chlorella vulgaris Depends on the Surface-Stabilizing Agent. Nanomaterials 2023, 13, 1967. [Google Scholar] [CrossRef] [PubMed]
- Yin, I.X.; Zhang, J.; Zhao, I.S.; Mei, M.L.; Li, Q.; Chu, C.H. The Antibacterial Mechanism of Silver Nanoparticles and Its Application in Dentistry. Int. J. Nanomed. 2020, 15, 2555–2562. [Google Scholar] [CrossRef] [PubMed]
- Sakagami, H.; Ohkoshi, E.; Amano, S.; Satoh, K.; Kanamoto, T.; Terakubo, S.; Nakashima, H.; Sunaga, K.; Otsuki, T.; Ikeda, H.; et al. Efficient utilization of plant resources by alkaline extraction. Altern. Integ. Med. 2013, 2, 7. [Google Scholar] [CrossRef]
- Ohno, H.; Miyoshi, S.; Araho, D.; Kanamoto, T.; Terakubo, S.; Nakashima, H.; Tsuda, T.; Sunaga, K.; Amano, S.; Ohkoshi, E.; et al. Efficient utilization of licorice root by alkaline extraction. In Vivo 2014, 28, 785–794. [Google Scholar] [PubMed]
- Shaik, M.R.; Khan, M.; Kuniyil, M.; Al-Warthan, A.; Alkhathlan, H.Z.; Siddiqui, M.R.H.; Shaik, J.P.; Ahamed, A.; Mahmood, A.; Khan, M.; et al. Plant-extract-assisted green synthesis of silver nanoparticles using Origanum vulgare L. Extract and Their Microbicidal Activities. Sustainability 2018, 10, 913. [Google Scholar] [CrossRef]
- Wang, H.; Qiao, X.; Chen, J.; Ding, S. Preparation of silver nanoparticles by chemical reduction method. Colloids Surf. A Physicochem. Eng. Asp. 2005, 256, 111–115. [Google Scholar] [CrossRef]
- Sharifi-Rad, M.; Pohl, P.; Epifano, F. Phytofabrication of silver nanoparticles (AgNPs) with pharmaceutical capabilities using Otostegia persica (Burm.) Boiss. Leaf Extract. Nanomaterials 2021, 11, 1045. [Google Scholar] [CrossRef]
- Al-Otibi, F.; Al-Zahrani, R.M.; Marraiki, N. Biodegradation of selected hydrocarbons by fusarium species isolated from contaminated soil samples in Riyadh, Saudi Arabia. J. Fungi 2023, 9, 216. [Google Scholar] [CrossRef]
- Balouiri, M.; Sadiki, M.; Ibnsouda, S.K. Methods for in vitro evaluating antimicrobial activity: A review. J. Pharm. Anal. 2016, 6, 71–79. [Google Scholar] [CrossRef]
- Matotoka, M.M.; Mashabela, G.T.; Masoko, P. Phytochemical content, antibacterial activity, and antioxidant, anti-inflammatory, and cytotoxic effects of traditional medicinal plants against respiratory tract bacterial pathogens. Evid. Based Complement. Alternat. Med. 2023, 2023, 1243438. [Google Scholar] [CrossRef]
- López-Lorente, A.I.; Mizaikoff, B. Recent advances on the characterization of nanoparticles using infrared spectroscopy. TrAC, Trends Anal. Chem. 2016, 84, 97–106. [Google Scholar] [CrossRef]
- Naidoo, C.M.; Naidoo, Y.; Dewir, Y.H.; Murthy, H.N.; El-Hendawy, S.; Al-Suhaibani, N. Major bioactive alkaloids and biological activities of Tabernaemontana species (Apocynaceae). Plants 2021, 10, 313. [Google Scholar] [CrossRef] [PubMed]
- Altammar, K.A. A review on nanoparticles: Characteristics, synthesis, applications, and challenges. Front. Microbiol. 2023, 14, 1155622. [Google Scholar] [CrossRef] [PubMed]
- Joudeh, N.; Linke, D. Nanoparticle classification, physicochemical properties, characterization, and applications: A comprehensive review for biologists. J. Nanobiotech. 2022, 20, 262. [Google Scholar] [CrossRef] [PubMed]
- Zhang, X.F.; Liu, Z.G.; Shen, W.; Gurunathan, S. Silver nanoparticles: Synthesis, characterization, properties, applications, and therapeutic approaches. Int. J. Mol. Sci. 2016, 17, 1534. [Google Scholar] [CrossRef] [PubMed]
- Rahman, H.; Rauf, A.; Khan, S.A.; Ahmad, Z.; Alshammari, A.; Alharbi, M.; Alam, A.; Suleria, H.A.R. Green synthesis of silver nanoparticles using Rhazya stricta Decne extracts and their anti-microbial and anti-oxidant activities. Crystals 2023, 13, 398. [Google Scholar] [CrossRef]
- Seif, A. Phytochemical, antioxidant, and antimicrobial effects of methanolic leaf extract of Rhazya stricta decne. Int. J. Res. Med. Sci. 2022, 10, 293–300. [Google Scholar] [CrossRef]
- Aziz, A.T.; Alshehri, M.A.; Alanazi, N.A.; Panneerselvam, C.; Trivedi, S.; Maggi, F.; Sut, S.; Dall’Acqua, S. Phytochemical analysis of Rhazya stricta extract and its use in fabrication of silver nanoparticles effective against mosquito vectors and microbial pathogens. Sci. Total Environ. 2020, 700, 134443. [Google Scholar] [CrossRef]
- Bawazeer, S.; Rauf, A.; Bin Emran, T.; Aljohani, A.S.M.; Alhumaydhi, F.A.; Khan, Z.; Ahmad, L.; Hemeg, H.A.; Muhammad, N.; Sharma, R.; et al. Biogenic synthesis of silver nanoparticles using Rhazya stricta extracts and evaluation of its biological activities. J. Nanomater. 2022, 2022, 7365931. [Google Scholar] [CrossRef]
- Zhou, W.; Su, M.; Cai, X. Advances in nanoparticle sizing in suspensions: Dynamic light scattering and ultrasonic attenuation spectroscopy. KONA Powder Part. J. 2017, 34, 168–182. [Google Scholar] [CrossRef]
- Zhangabay, Z.; Berillo, D. Antimicrobial and antioxidant activity of AgNPs stabilized with Calendula officinalis flower extract. Results Surf. Interfaces 2023, 11, 100109. [Google Scholar] [CrossRef]
- Panneerselvam, R.; Xiao, L.; Waites, K.B.; Atkinson, T.P.; Dluhy, R.A. A rapid and simple chemical method for the preparation of Ag colloids for surface-enhanced Raman spectroscopy using the Ag mirror reaction. Vib. Spectrosc. 2018, 98, 1–7. [Google Scholar] [CrossRef] [PubMed]
- Rauwel, P.; Küünal, S.; Ferdov, S.; Rauwel, E. A Review on the green synthesis of silver nanoparticles and their morphologies studied via TEM. Adv. Mater. Sci. Eng. 2015, 2015, 682749. [Google Scholar] [CrossRef]
- Hashem, A.H.; Saied, E.; Amin, B.H.; Alotibi, F.O.; Al-Askar, A.A.; Arishi, A.A.; Elkady, F.M.; Elbahnasawy, M.A. Antifungal activity of biosynthesized silver nanoparticles (AgNPs) against Aspergilli causing Aspergillosis: Ultrastructure Study. J. Funct. Biomater. 2022, 13, 242. [Google Scholar] [CrossRef] [PubMed]
- Hermosilla, E.; Díaz, M.; Vera, J.; Seabra, A.B.; Tortella, G.; Parada, J.; Rubilar, O. Molecular weight identification of compounds involved in the fungal synthesis of AgNPs: Effect on antimicrobial and photocatalytic activity. Antibiotics 2022, 11, 622. [Google Scholar] [CrossRef] [PubMed]
- Khan, S.; Khan, G.M. In vitro antifungal activity of Rhazya stricta. Pak. J. Pharm. Sci. 2007, 20, 279–284. [Google Scholar] [PubMed]
- Hassan, M.M.; Albogami, B.; Mwabvu, T.; Awad, M.F.; Kadi, R.H.; Mohamed, A.A.; Al-Orabi, J.A.; Hassan, M.M.; Elsharkawy, M.M. The Antibacterial Activity of Rhazya stricta Extracts against Klebsiella pneumoniae Isolated from Some Soil Invertebrates at High Altitudes. Molecules. 2023, 28, 3613. [Google Scholar] [CrossRef] [PubMed]
- Khan, R.; Baeshen, M.N.; Saini, K.S.; Bora, R.S.; Al-Hejin, A.M.; Baeshen, N.A. Antibacterial activities of Rhazya stricta leaf extracts against multidrug-resistant human pathogens. Biotechnol. Biotechnol. Equip. 2016, 30, 1016–1025. [Google Scholar] [CrossRef]
- Beigomi, M.; Shahraki-Mojahed, L.; Heydari-Sadegh, B.; Dahmardeh, N.; Rouhani, R.; Javadian, F. Evaluation of antimicrobial activity of Rhazya stricta (Apocynaceae) extract prepared with different solvents on Staphylococcus aureus (Staphylococcaceae) isolated from humans. Int. J. Adv. Biol. Biomed. Res. 2021, 9, 241–253. [Google Scholar] [CrossRef]
- Asadian, M.; Zarei, H.; Fakheri, B.A.; Fahmideh, L. Evaluation of antimicrobial activity of essential oil of eshvark (Rhazya stricta) against two strains of Staphylococcus aureus and Listeria monocytogenes. Int. J. Infect. 2017, 4, e61912. [Google Scholar] [CrossRef]
- Perveen, K.; Bokhari, N.A.; Siddiqui, I.; Wahibi, M.S. In vitro antimicrobial activity of some medicinal plants found in Saudi Arabia. J. Pure Appl. Microbiol. 2014, 8, 2129–2134. [Google Scholar]

| Compound Class | Functional Group | Aq-Extract | Alk-Extract | Aq-AgNPs | Alk-AgNPs |
|---|---|---|---|---|---|
| Alcohol | -hydroxyl (O-H stretching) | 3757.33; 3387.00 | 3757.33; 3379.29 | 3752.67; 3404.07 | 3752.74; 3430.84 |
| Alkane | -alkyl (C-H stretching) | 2931.8 | 2947.23 | 2943.23 | |
| Secondary amine halide salts | NH2+ stretches | 2376.3 | |||
| Isocyanate | N=C=O stretching | 2283.72 | 2283.72 | ||
| Aldehyde | C=O stretching | 1728.22 | |||
| Alkene | -alkenyl (C=C stretching) | 1638.69 | |||
| Amine | -amino (N-H bending) | 1612.49 | 1635.64 | 1601.15 | |
| Carboxylic acid | Carboxyl (O-H bending) | 1427.32 | 1442.75, 1411.89 | 1433.71 | 1386 |
| Nitrile | Cyano (C-N stretching) | 1288.45, 1203.58, 1072.42 | 1242.16, 1072.42 | 1073.06 | 1071.57 |
| Alkene | alkenyl (C=C bending) | 887.26 | 894.97 | ||
| Halo compounds | C-Br or C-I stretching | 748.38, 609.51, 540.07 | 717.52, 601.79, 532.35 | 746.45, 611.4 | 839.02, 617.91 |
| Concentration | 0% | 5% | 10% | 20% | Previcur Energy (Fungicide) | |||||
|---|---|---|---|---|---|---|---|---|---|---|
| GA * | IMG% | GA * | IMG% | GA * | IMG% | GA * | IMG% | GA * | IMG% | |
| R. stricta Aq-extract | ||||||||||
| F. solani | 50.27 ± 0.0 | 0.0 | 47.12 ± 0.0 | 25.0 | 46.87± 0.05 | 26.0 | 46.29 ± 0.0 | 28.1 | 48.3 ± 0.1 | 19.8 |
| p-value # | 1 | 0.66 | 0.63 | 0.57 | <0.001 # | |||||
| F. verticillioides | 50.27 ± 0.0 | 0.0 | 47.12 ± 0.0 | 25.0 | 47.12 ± 0.07 | 25 | 46.57 ± 0.0 | 27.1 | 49.35 ± 0.06 | 13.5 |
| p-value # | 1 | 0.03# | 0.66 | 0.60 | <0.001 # | |||||
| F. proliferatum | 50.27 ± 0.0 | 0.0 | 47.12 ± 0.07 | 25 | 43.57 ± 0.0 | 37.536.5 | 43.2 ± 0.0 | 37.5 | 49.48 ± 0.0 | 12.5 |
| p-value # | 1 | 0.66 | 0.34 | 0.32 | <0.001 # | |||||
| F. incarnatum | 50.27 ± 0.0 | 0.0 | 49.19 ± 0.08 | 14.6 | 48.3 ± 0.07 | 19.8 | 48.3 ± 0.06 | 19.8 | 50.27 ± 0.0 | 0.0 |
| p-value # | 1 | 0.88 | 0.78 | 0.78 | 1 | |||||
| R. stricta Alk-extract | ||||||||||
| F. solani | 50.27 ± 0.0 | 0.0 | 11.78 ± 0.0 | 87.5 | 0.0 ± 0.0 | 100 | 0.0 ± 0.0 | 100 | 48.3 ± 0.1 | 19.8 |
| p-value # | 1 | <0.001 # | <0.001 # | <0.001 # | <0.001 # | |||||
| F. verticillioides | 50.27 ± 0.0 | 0.0 | 11.78 ± 0.0 | 87.5 | 0.0 ± 0.0 | 100 | 0.0 ± 0.0 | 100 | 49.35 ± 0.06 | 13.5 |
| p-value # | 1 | <0.001 # | <0.001 # | <0.001 # | <0.001 # | |||||
| F. proliferatum | 50.27 ± 0.0 | 0.0 | 11.78 ± 0.0 | 75.587.5 | 0.0 ± 0.0 | 100 | 0.0 ± 0.0 | 100 | 49.48 ± 0.0 | 12.5 |
| p-value # | 1 | <0.001 # | <0.001 # | <0.001 # | <0.001 # | |||||
| F. incarnatum | 50.27 ± 0.0 | 0.0 | 11.78 ± 0.0 | 87.5 | 0.0 ± 0.0 | 100 | 0.0 ± 0.0 | 100 | 50.27 ± 0.0 | 0.0 |
| p-value # | 1 | 0.561 | 0.561 | <0.001 # | 1 | |||||
| Concentration | 0% | 25% | 50% | 75% | 100% | Previcur Energy (Fungicide) | ||||||
|---|---|---|---|---|---|---|---|---|---|---|---|---|
| Growth * | IMG% | Growth * | IMG% | Growth * | IMG% | Growth * | IMG% | Growth * | IMG% | Growth * | IMG% | |
| R. stricta Aq-AgNPs | ||||||||||||
| F. solani | 50.27 ± 0.0 | 0.0 | 34.71 ± 0.0 | 55.6 | 30.63 ± 0.0 | 62.5 | 26.51. ± 0.0 | 68.75 | 24.03 ± 0.0 | 72.3 | 48.3 ± 0.1 | 19.8 |
| p-value # | 1 | <0.001 # | <0.001 # | <0.001 # | <0.001 # | <0.001 # | ||||||
| F. verticillioides | 50.27 ± 0.0 | 0.0 | 37.7 ± 0.0 | 50.0 | 32.54 ± 0.0 | 59.4 | 30.63 ± 0.0 | 62.5 | 30.63 ± 0 | 62.5 | 49.35 ± 0.06 | 13.5 |
| p-value # | 1 | <0.001 # | <0.001 # | <0.001 # | <0.001 # | <0.001 # | ||||||
| F. proliferatum | 50.27 ± 0.0 | 0.0 | 33.28 ± 0.07 | 58.1 | 26.51 ± 0.0 | 68.8 | 21.99 ± 0.0 | 75.0 | 21.99 ± 0.0 | 75.0 | 49.48 ± 0.0 | 12.5 |
| p-value # | 1 | <0.001 # | <0.001 # | <0.001 # | <0.001 # | <0.001 # | ||||||
| F. incarnatum | 50.27 ± 0.0 | 0.0 | 21.99 ± 0.0 | 75.0 | 11.78 ± 0.0 | 87.5 | 11.78 ± 0.0 | 87.5 | 10.011.78 ± 0.0 | 87.5 | 50.27 ± 0.0 | 0.0 |
| p-value # | 1 | <0.001 # | <0.001 # | <0.001 # | <0.001 # | 1 | ||||||
| R. stricta Alk-AgNPs | ||||||||||||
| F. solani | 50.27 ± 0.0 | 0.0 | 43.2 ± 0.0 | 37.5 | 43.2 ± 0.0 | 37.5 | 43.2 ± 0.0 | 37.5 | 43.2 ± 0.0 | 37.5 | 48.3 ± 0.1 | 19.8 |
| p-value # | 1 | <0.001 # | <0.001 # | <0.001 # | <0.001 # | <0.001 # | ||||||
| F. verticillioides | 50.27 ± 0.0 | 0.0 | 43.2 ± 0.0 | 37.5 | 43.2 ± 0.0 | 37.5 | 43.2 ± 0.0 | 37.5 | 43.2 ± 0.0 | 37.5 | 49.35 ± 0.06 | 13.5 |
| p-value # | 1 | <0.001 # | <0.001 # | <0.001 # | <0.001 # | <0.001 # | ||||||
| F. proliferatum | 50.27 ± 0.0 | 0.0 | 47.12 ± 0.14 | 25 | 46.87 ± 0.0 | 26 | 46.57 ± 0.07 | 26.027.1 | 46 ± 0.07 | 29.1 | 49.48 ± 0.0 | 12.5 |
| p-value # | 1 | <0.001 # | <0.001 # | <0.001 # | <0.001 # | <0.001 # | ||||||
| F. incarnatum | 50.27 ± 0.0 | 0.0 | 22.74 ± 0.13 | 74.0 | 17.89 ± 1.40.07 | 80.3 | 14.48 ± 2.50.13 | 84.4 | 12.511.78 ± 0.13 | 84.487.5 | 50.27 ± 0.0 | 0 |
| p-value # | 1 | <0.001 # | <0.001 # | <0.001 # | <0.001 # | 1 | ||||||
Disclaimer/Publisher’s Note: The statements, opinions and data contained in all publications are solely those of the individual author(s) and contributor(s) and not of MDPI and/or the editor(s). MDPI and/or the editor(s) disclaim responsibility for any injury to people or property resulting from any ideas, methods, instructions or products referred to in the content. |
© 2023 by the author. Licensee MDPI, Basel, Switzerland. This article is an open access article distributed under the terms and conditions of the Creative Commons Attribution (CC BY) license (https://creativecommons.org/licenses/by/4.0/).
Share and Cite
Al-Otibi, F. The Antifungal Activities of Silver Nano-Aggregates Biosynthesized from the Aqueous Extract and the Alkaline Aqueous Fraction of Rhazya stricta against Some Fusarium Species. Nanomaterials 2024, 14, 88. https://doi.org/10.3390/nano14010088
Al-Otibi F. The Antifungal Activities of Silver Nano-Aggregates Biosynthesized from the Aqueous Extract and the Alkaline Aqueous Fraction of Rhazya stricta against Some Fusarium Species. Nanomaterials. 2024; 14(1):88. https://doi.org/10.3390/nano14010088
Chicago/Turabian StyleAl-Otibi, Fatimah. 2024. "The Antifungal Activities of Silver Nano-Aggregates Biosynthesized from the Aqueous Extract and the Alkaline Aqueous Fraction of Rhazya stricta against Some Fusarium Species" Nanomaterials 14, no. 1: 88. https://doi.org/10.3390/nano14010088
APA StyleAl-Otibi, F. (2024). The Antifungal Activities of Silver Nano-Aggregates Biosynthesized from the Aqueous Extract and the Alkaline Aqueous Fraction of Rhazya stricta against Some Fusarium Species. Nanomaterials, 14(1), 88. https://doi.org/10.3390/nano14010088

